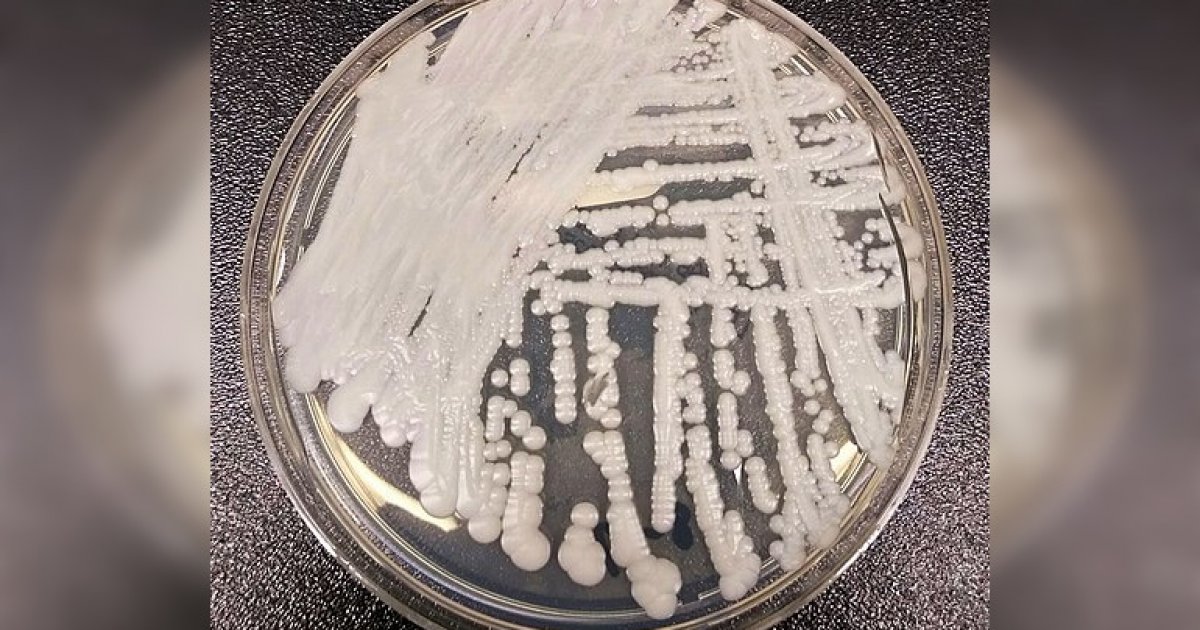

A new study by icddr,b has found that a highly drug-resistant fungal “superbug” called Candida auris is spreading within neonatal intensive care units (NICUs) in Bangladesh, posing a serious threat to newborns and healthcare systems.
Published in the journal “Microbiology Spectrum”, the study was conducted by researchers from the International Centre for Diarrhoeal Disease Research, Bangladesh (icddr,b) in collaboration with the Institute of Epidemiology, Disease Control and Research (IEDCR), and with technical support from the US Centers for Disease Control and Prevention (CDC).
Candida auris is a fungus that can live harmlessly on human skin but sometimes enters the bloodstream, leading to deadly infections.
In low- and middle-income countries, infections caused by C auris can result in a crude mortality rate of up to 70%.
The fungus poses particular danger to preterm and critically ill babies as well as to individuals with weakened immune systems.
Between August 2021 and September 2022, researchers studied 374 infants admitted to NICUs in one public and one private hospital in Dhaka.
They found that 32 babies (9%) were colonized with C auris, while one baby (0.3%) developed a bloodstream infection. More than half of those colonized (56%) acquired the fungus after being admitted, suggesting significant in-hospital transmission.
The study also revealed that 82% of the fungal isolates were resistant to fluconazole, the most common antifungal drug. Although only 9% showed multidrug resistance, the researchers warned that C auris can persist for long periods on hospital surfaces and spread rapidly, making it a major healthcare-associated “superbug.”
Seven of the 32 infected infants, including the one with bloodstream infection, died during the study period.
Most colonized infants (81%) were delivered via cesarean section, suggesting prolonged hospital stays might increase exposure risk.
“This study provides important evidence of transmission of this superbug among critically ill and vulnerable patients in NICUs,” said Dr Fahmida Chowdhury, associate scientist and lead of the AMR Research Unit at icddr,b.
“It is a necessary first step toward implementing preventive measures at the administrative and policy levels,” she added.
The authors recommended regular cleaning of hospital surfaces with chlorine-based disinfectants, improved hand hygiene among healthcare workers, and continuous surveillance to detect and isolate colonized or infected infants promptly.
They urged authorities to take immediate preventive action to curb the spread of this emerging healthcare-associated threat in Bangladesh.